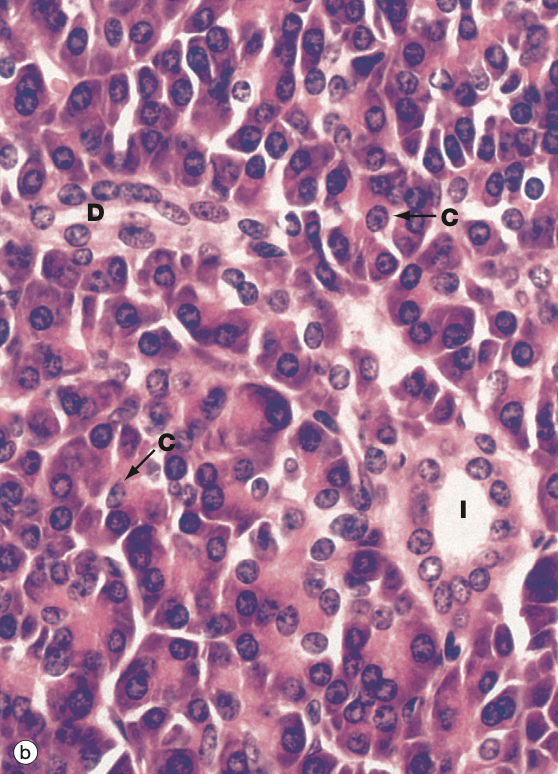
<p>Identify the Organ and Structures?</p>

Lec 14 GI Accessory Glands & Organs: Biol 302 Histology Midterm #2
1/45
There's no tags or description
Looks like no tags are added yet.
Name | Mastery | Learn | Test | Matching | Spaced | Call with Kai |
|---|
No analytics yet
Send a link to your students to track their progress
46 Terms

What are the Accessory Glands?
Liver, Gall bladder, Pancreas
Functions of Liver?
Production of bile, hor, serum proteins
Detoxification of blood
Storage of nut and Vit A
Phagocytosis of debris and dead cells
Blood supply (aff = portal vein and hepatic artery…eff = hepatic vein)
Breakdown the Liver structure?
Mesothelium; simple squam epit w/ DICT below
Glisson’s capsule surr whole liver (collagenous T)
Lobule = Hepatocytes + Sinusoids + Central Vein + Portal Triad (Portal venule, Hepatic arterioles, Bile ductules…Lymphatic vessels)


Identify the Organ and Structures?
Liver; Mesothelium, Hepato, Sinu

Identify the Organ and Structures?
Liver; Lobule w/ Central vein, surr by Hepato and Sinu, Portal triads in corners

Identify the Organ and Structures?
Liver; Lobule w/ Central vein, surr by Hepato and Sinu, Portal triads in corners

Identify the Organ and Structures?
Liver; Lobule w/ Central vein, surr by Hepato and Sinu, Portal triads in corners

Identify the Organ and Structures?
Liver; Lobule w/ Central vein, surr by Hepato and Sinu, Portal triads in corners

Identify the Organ and Structures?
Liver; Central vein, surr by Hepato and Sinu
What is in the Portal Triad?
Portal venule (simple squam), Hepatic arterioles (simple cuboidal), Bile ductules…Lymphatic vessels

Identify the Organ and Structures?
Liver; Lobule w/ Central vein, surr by Hepato and Sinu, Portal triads in corners
D = Pv on top, Bd on left, Ha on right, C = Bd

Identify the Organ and Structures?
Liver;
1 = Bile duct
2 = Hepatocytes
3 = Sinusoids
4 = Portal Vein
5 = Hepatic arteriole

Identify the Organ and Structures?
Liver;
1 = Ha
2 = Ha
3 = Bd
4 = Bd
5 = Bd
6 = Pv
7 = Pv
Function of Hepatocytes?
abs and processing of nutrients
prod and sec of plasma prot and bile
How is bile made?
Hepato → bile cancaliculae → bile ductules → common hepatic D → Gallbladder → common bile D → Duodenum

Identify the Organ and Structures?
Liver; Hepatocytes (polyploidy)

Identify the Organ and Structures?
Liver; Lines are bile canaliculae, lighter areas = Sinusoids, darker areas with nuc = Hepato

Identify the Organ and Structures?
Liver; reticulin f and how it holds Hepatocytes tgth

Identify the Organ and Structures?
Liver; bile canaliculae

Identify the Organ and Structures?
Liver; bile ductules w/ simple cuboidal epit

Identify the Organ and Structures?
Liver; bile ductules w/ simple cuboidal epit
Function of Sinusoids?
modified capi that are discontinuous and look fenestrated
they deliver nutrients and pick up proteins

Identify the Organ and Structures?
Liver;
1 = Space of Disse
2 = Sinusoid
3 = Endothelium (simple squam)
4 = Hepatocyte

Identify the Organ and Structures?
Liver; sinusoids (simple squam)
Function of Space of Disse?
intimate contact w/ hepatocyte MV and sinusoid, support is reticular f/Stroma

Identify the Organ and Structures?
Liver; MV of hepato next to dark on the L, D = space of Disse, L of cow print is endothelium of suni
Function of Kupffer cell?
macrophage that removes debris and erythrocytes, needs trypan blue


Identify the Organ and Structures?
Liver; dark cells are Kupffer cell, Sinu

Identify the Organ and Structures?
Liver; lighter areas = Sinusoids, darker areas with nuc = Hepato, darker spots = Kupffer cells
Function of Gallbladder?
storage and concentration of bile, comes from liver via Hepatic D, then leaves via common Bile D to SI
Abs w/ MV on simple columnar epit


Identify the Organ and Structures?
Gallbladder; can see finger like Villi w/ holes, also see simple columnar epit below MV
Function of Pancreas?
mixed (mostly exo) Glands that sec zymogens and bicarbonate. Have islets of langerhans
Breakdown the Pancreas glands
the G is a compound acinar G; acinus = secretory, duct = transport and modification
acini portion → small cavity surr by secre cells of trypsinogen and Golgi
duct portion → intercalated D, intraobular D, pancreatic D

Endocrine in Pancreas?
Islets of Langerhans (lighter areas)
Beta Cells - insulin
Alpha Cells - glucagon
Delta Cells - somatostatin
PP Cells - pancreatic polypeptide

Identify the Organ and Structures?
Pancreas; (splotchy) islets of langerhans (lighter), acinar G (darker outside)

Identify the Organ and Structures?
Pancreas; acinar G looks like flower

Identify the Organ and Structures?
Liver; Mesothelium, Hepato, Sinu

Identify the Organ and Structures?
Liver; Hepatocytes, some being binucleate which is common

Identify the Organ and Structures?
Liver; Hepatocytes, some being binucleate which is common

Identify the Organ and Structures?
Liver; reticulin f and how it holds Hepatocytes tgth

Identify the Organ and Structures?
Liver; Lobule w/ Central vein, surr by Hepato and Sinu, Portal triads in corners

Identify the Organ and Structures?
Gallbladder; can see finger like Villi but holes not rlly seen?

Identify the Organ and Structures?
Pancreas; (splotchy) islets of langerhans (lighter), acinar G (darker outside)

Identify the Organ and Structures?
Pancreas; acinar/exocrine G (flower)
Identify the Organ and Structures?
Harder for me…Pancreas; (splotchy) islets of langerhans (lighter), acinar G (darker outside)

Identify the Organ and Structures?
Pancreas; (splotchy) islets of langerhans (lighter), acinar G (darker outside)